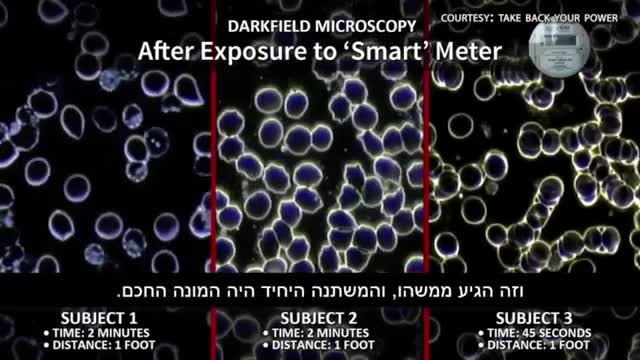

Premium Only Content
This video is only available to Rumble Premium subscribers. Subscribe to
enjoy exclusive content and ad-free viewing.
האמת אודות קרינה ודילול אוכלוסין
Loading comments...
-
1:54
Covid News Updates &whistleblower | ערוץ קוביד חדשות עדכונים וחושפי שחיתויות
12 hours agoרן כליף שהיה מנהל בכללית מספר איך דחפו חיסוני שפעת שעמדו לפוג תוקף רק כדי לא לאבד את התקציב לא בשביל הבריאות שם איבד אמון בממסד
50 -
1:00:21
Akademiks
1 hour agonba youngboy live show.
6.13K -
LIVE
The Quartering
1 hour agoThey Just Stopped Another Attack, Trump Defeats Youtube, Hasan PIker Meltdown & More
1,813 watching -
8:54:37
Dr Disrespect
10 hours ago🔴LIVE - DR DISRESPECT - BABY STEPS - TO THE TIPPITY TOP
177K16 -
LIVE
Drew Hernandez
7 hours agoTRUMP'S NEW GAZA PEACE PLAN & NETANYAHU LAUNCHES NEW SOCIAL MEDIA OP
619 watching -
LIVE
FreshandFit
8 hours agoMoney Monday Call-In Show w/ Steve From Accounting
1,117 watching -
3:07:28
Nikko Ortiz
4 hours agoArena Breakout Better Than Tarkov? - Rumble LIVE
32.6K2 -
35:44
MattMorseTV
3 hours ago $10.17 earned🔴Schumer just WALKED INTO Trump's TRAP.🔴
31.2K57 -
2:41:44
BubbaMatt
12 hours ago $0.46 earnedMafia Definitive Edition Playthrough - Part 5
13.7K1 -
51:25
Donald Trump Jr.
4 hours agoAmerica First in Action, All the Latest News | TRIGGERED Ep.278
124K112